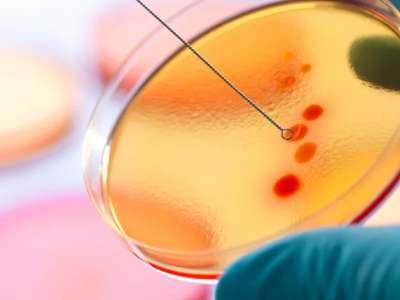
Historia de la Microbiologia

Principales Epidemias de la Historia:Virus y Propagación
Principales Epidemias de la Historia
¿Por qué estudiar las pestes del pasado? La historia de las epidemias es, en realidad, la historia de la resistencia humana. Cada plaga mencionada en este cronograma —desde la crisis en la Atenas de Pericles hasta la globalización del Cólera— obligó a las sociedades a transformarse.
Las pandemias han sido motores de cambio:
Impulsaron el nacimiento de la sanidad pública y el tratamiento del agua.
Provocaron el colapso del feudalismo tras la Peste Negra, mejorando el valor del trabajo manual.
Obligaron al desarrollo de las primeras vacunas y antibióticos.
Entender cómo nuestros antepasados sobrevivieron a estos "enemigos invisibles" nos permite comprender mejor la fragilidad de nuestra propia civilización y la importancia del progreso científico.
 Peste en Atenas
Peste en Atenas  Peste en Roma
Peste en Roma  Peste en Bizancio
Peste en Bizancio  La Peste Negra
La Peste Negra  Gripe Española
Gripe Española  Viruela en América
Viruela en América  Gripe Asiática
Gripe Asiática
Una enfermedad infecciosa nueva —a la que no nos habíamos enfrentado nunca antes— que se disemina de manera global y tiene una alta incidencia de morbilidad (enfermedad) y de mortalidad fue descripta, durante los últimos trescientos años, como una "pandemia".
La palabra procede de pan (totalidad) y demos (gente, o población).
Una pandemia, entonces, afecta a todos los seres humanos.
El virus de la influenza de 1918-1919, por ejemplo, se extendió por todo el planeta, sin distinguir etnias, ubicación geográfica, sistemas de valores culturales ni clases sociales.
Hasta hace muy poco, la medida principal para determinar que estábamos en presencia de una nueva enfermedad de estas características consistía únicamente en monitorear el contagio masivo de síntomas extraños y por lo general molestos.
Antes de que se afianzara la teoría microbiana de las enfermedades (entre mediados y fines del siglo XIX), e incluso hasta varios años después, sólo podíamos basarnos en la prevalencia y en la severidad del cuadro clínico.
Hoy en día la situación es completamente distinta: nuestra capacidad para descifrar los secretos de las enfermedades infecciosas, y el avance en las tecnologías de investigación y de diagnóstico llevan ciento cincuenta años de constante evolución.
Fueron mejorando de forma gradual más o menos hasta la década de 1980, y luego, durante los últimos treinta años, la revolución de la biología molecular aportó un impulso cada vez más intenso.
La ciencia del presente nos ofrece diversos tests y pruebas de laboratorio que nos permiten identificar el organismo causante de cualquier enfermedad, de manera rápida y conclusiva.
El incremento de la población y de los viajes ha creado las condiciones ideales para la propagación de enfermedades, nuevas y existentes.
Algunas han sido contenidas, pero otras amenazan con convertirse en epidemias globales, o pandemias.
La Organización Mundial de la Salud (OMS) vigila numerosas enfermedades que causan importantes pérdidas de vidas o que amenazan con hacerlo si no se mantienen bajo control.
Algunas, como la malaria y la tuberculosis, son viejas enemigas de la humanidad.
Otras son más recientes y proceden de virus que han cruzado la barrera entre especies de animales a humanos.
El síndrome de inmunodeficiencia adquirida, o sida, es causado por el virus de la inmunodeficiencia humana (VIH).
Se cree que este evolucionó a partir del virus de inmunodeficiencia en simios (VIS), que existe entre los primates no humanos africanos desde hace millones de años.
Parece ser que, a principios del s. XX, este virus saltó de un chimpancé infectado a un huésped humano y mutó en VIH, una forma que puede transmitirse entre las personas.
El VIH se propagó sin ser detectado durante décadas hasta que, al inicio de la década de 1980, se dio una serie de casos de sida en EE UU.
Desde ese momento se ha propagado por todo el mundo y ha causado la muerte de más de dos millones de personas.
Fue finalmente desenmascarado como agente causante del sida en 1983 por el virólogo francés Luc Montaigner.
►Epidemias Emergentes
Una vez declarado el brote epidémico, hay muchos factores que pueden afectar su curso.
A veces, el organismo causante es tan mortífero que de hecho se controla por sí mismo matando a su huésped antes de extenderse más.
Este es el caso del virus hemorrágico Ébola, de Zaire, uno de los agentes patógenos más letales conocidos.
Identificado en la década de 1970, está restringido casi por completo al África tropical, donde se producen brotes cada pocos años.
Las enfermedades respiratorias, como la gripe y el síndrome respiratorio agudo severo (SRAS), presentan una situación distinta.
Estas enfermedades se propagan a través de gotitas de moco suspendidas en el aire, y dado que sus sintomas iniciales no son tan incapacitantes como para recluir a la gente en su casa, puede extenderse con suma rapidez.
La pandemia de 2009 de gripe H1N1 se originó en México y desde ese momento los viajeros aéreos la llevaron al resto del mundo en cuestión de días.
A diferencia de los virus gripales, el VIH puede existir en el organismo durante años sin producir síntomas visibles.
Es más, durante su período latente se replica a una velocidad increíble: las células infectadas pueden liberar a la sangre 10.000 millones de virus en 24 horas. Sólo se transmite a través del contacto con fluidos corporales.
Lucha contra enfermedades virales
A pesar de este sombrío panorama, las vacunas han logrado algunos éxitos notables. Un ejemplo es la viruela, que fue erradicada en 1979 , y los casos de poliomielitis han descendido un 99% en las últimas dos décadas.
La fiebre amarilla puede prevenirse, y en los próximos diez años se espera una vacuna contra la malaria.
En el caso de la gripe, los programas de vacunación basados en las variantes ya conocidas ayudan a controlar las epidemias invernales, pero no es posible almacenar reservas contra las variantes nuevas.
Los antivirales pueden inhibir el desarrollo del virus, pero no lo destruyen.
El retrovirus VIH continúa siendo un adversario sin vacuna a la vista.
Es más, apunta a células del sistema inmunitario (en particular las T4), el arma que el organismo utiliza para defenderse.
Sin embargo, a finales de la década de 1980 se obtuvieron antirretrovirales que previenen la replicación del VIH en las células vivas.
Hoy, estos fármacos se administran en combinaciones de tres o cuatro tipos.
Este tratamiento se dirige a distintas fases del ciclo de replicación, reduciendo de este modo la resistencia a cualquier otro fármaco concreto, que es uno de los mayores inconvenientes en la lucha contra la enfermedad.
PRINCIPALES EPIDEMIAS Y PANDEMIAS
La peste es el prototipo de la enfermedad mortal, millones de personas han muerto víctimas de ella.
Entre 1860 y 1930 todavía perecieron por su causa unas 12.000.000 de personas enfermas, actualmente según datos de la OMS (Organización Mundial de la Salud) la contraen cerca de 2000 personas por año y dicha cifra va en aumento.
Un agente infeccioso fácilmente detectable que —como en el caso del virus de la gripe porcina de 2009— tienda a provocar una enfermedad por lo general leve en la mayoría de la gente, pero que se disemina con rapidez por todo el planeta, será descripto, según los criterios actuales, como causa de pandemia.
Y es aquí donde pueden surgir ciertas confusiones: la sensación general indica que "pandemia" es sinónimo de catástrofe.
Cuando tanto los medios de comunicación como el público en general se dieron cuenta de que en definitiva la pandemia de gripe porcina de 2009 no resultaba más peligrosa que, digamos, la epidemia de influenza "estacional" común de todos los años, muchos sintieron que las autoridades, sobre todo las de salud pública, habían exagerado en exceso el grado de peligro.
Las pandemias infecciosas son, por definición, problemas globales a los que ningún Estado-nación puede enfrentar solo.
Los encargados de declarar si hay una pandemia en curso son los epidemiólogos, los técnicos estadísticos y otros profesionales que trabajan para la Organización Mundial de la Salud (OMS), con sede central en Ginebra, Suiza.
• Epidemia:
La epidemia se define como una enfermedad que se propaga durante algún tiempo por un país, acometiendo simultáneamente a gran número de personas.
• Pandemia:
La pandemia se define como una enfermedad epidémica que se extiende a muchos países o que ataca a casi todos los individuos de una localidad o región.
Antiguamente se conocía como pestilencia casi todo tipo de mortandad generalizada.
Hasta que en 1546 el médico italiano Cirolamo Fracastoro (1448-1553) pudo demostrar que realmente hay enfermedades contagiosas (de persona a persona, por portadores y por el aire), se pensaba que los responsables de la propagación de enfermedades eran el aire apestado y las emanaciones nocivas (miasma).
Pero el modo exacto en que se propagan las enfermedades se conoce gracias a los microbiólogos Louis Pastear (1822-1895)y Robert Koch (1843-1510).
El agente patógeno de la peste se descubrió a partir de las investigaciones que el médico y bacteriólogo suizo-francés Alexander Yersins (1863-1943) realizó en Hong Kong en 1894 junto con el japonés Shibasaburo Kitasatos (1853-1931).
►Primeras Muertes en Masa
En la Biblia ya se menciona la peste como castigo de Dios.
El poeta griego Homero describió plásticamente la rapidísima transmisión de la enfermedad (en griego loímos, nosos): «Apolo y Artemisa disparan a los hijos de Niobe con flechas apestadas» (Ilíada XXIV).
Los médicos de la Antigüedad se daban a la fuga cuando se desencadenaban las epidemias, pues sabían que no podían hacer nada.
La primera epidemia de peste documentada tuvo lugar en Constantinopla bajo el dominio del emperador Justiniano (527-565).

Posiblemente la introdujeron los barcos de Egipto en el año 542, y luego se extendió y costó la vida a miles de víctimas en muchos países. Gregorio de Tours (538/539-594), obispo e historiador, describió sus terribles consecuencias en Francia.
Los médicos se protegían con gabanes encerados y máscaras en forma de pico que estaban llenas de vinagre o hierbas.
Al parecer, también el agua de colonia Kólnisch Wasser 4711 que los hermanos Fariña vendían en Colonia se consideraba un agua contra la peste.
En Oberammergau, en 1634, se formuló una promesa: si la población se libraba de la enfermedad, se comprometía a representar la pasión de Jesús cada diez años.
Y así se sigue haciendo hasta hoy en día.
Desde este menú podrás acceder a diversas paginas que tratan este tema específicamente.
![]()
• El Virus Ébola
El virus Ébola es uno de los virus recientes que ha alcanzado más fama mundial.
Dos primeras cepas de este virus fueron identificadas por primera vez en el año 1976, al producirse epidemias de fiebre hemorrágica, en el Zaire y en Sudán, donde conjuntamente se registraron más de 550 casos y 430 muertes. Desde este primer episodio hubo otros casos en Costa de Marfil, Liberia y Gabón.
Durante el verano de 1995 se produjo en el Zaire una nueva epidemia importante de la primera cepa que afectó a 315 personas, de las cuales fallecieron 242.
Diecinueve años después del episodio de 1976, y con una distancia de 500 kilómetros, las cepas de virus aislados resultaban casi idénticas.
En 1989 se identificó una tercera cepa del virus Ébola en Reston, Arizona, donde cientos de monos importados de Filipinas fallecieron.
El virus Ébola/Reston parecía no provocar la enfermedad en el hombre, y aunque cuatro técnicos de laboratorio fueron infectados, ninguno de ellos desarrolló la enfermedad.
En 1994 se produjo un caso aislado de fiebre hemorrágica de Ébola, no mortal, en Costa de Marfil.
Un zoólogo europeo estaba realizando una autopsia a un chimpancé y resultó infectado por el virus que se identificó como la cuarta cepa, llamada Ébola/Tai Forest, que recibe el nombre del bosque de Tai en Costa de Marfil.
De todos los virus humanos causantes de enfermedades, el Ébola y su pariente, el virus Marburg, que también produce fiebre hemorrágica, son los únicos de los cuales se desconoce el hospedador y el ciclo biológico de transmisión.
Podrían estar involucrados otros mamíferos, aves, reptiles, insectos o garrapatas.
Las últimas investigaciones apuntarían a especies de monos colobos o a chimpancés.
A partir del primer caso registrado se sabe que la infección en el hombre se transmite por contacto directo, como el que se realiza entre médico, paciente y enfermera; y también se sabe que las condiciones hospitalarias poco higiénicas favorecen la propagación del virus, además de la tala de bosques y del comercio de monos para experimentación.
Para detectar material viral Ébola en la sangre o en los tejidos de los pacientes se utiliza una técnica denominada reacción en cadena de la polimera-sa, que duplica el material genético para su estudio.
Cuando se sospecha la infección por este virus se solicita, en forma inmediata, la colaboración de los expertos de la Organización Mundial de la Salud (OMS), de los centros para el Control y Prevención de Enfermedades (CDC) y de otros centros especializados para establecer las medidas de control epidémico.
El virus Ébola ha sido clasificado como de nivel cuatro de bioseguridad, el cual requiere establecer las medidas de máxima seguridad.
En la actualidad, se están realizando estudios detallados para comparar secuencias de ARN entre las distintas cepas de virus, y se espera obtener información adecuada que proporcione las claves sobre la historia natural y los hospedado-res de estos virus.
![]()
• ►PARA SABER MAS...
Enfermedades infectocontagiosas o transmisibles:
Son aquellas enfermedades producidas por un agente etiológico, caracterizadas por tener un período de infección, contagio e incubación.
La infección es la entrada de la noxa al organismo.
El contagio es la transmisión de la enfermedad de un individuo enfermo a uno sano, y esto puede ser en forma directa, por ejemplo a través de la microgota de flügge o indirecto por medio de utensilios, ropas o mediante un portador sano (alguien que aloja al agente pero no padece la enfermedad).
El período ¿e incubación tiene una duración variable y se extiende desde el momento del contagio hasta la aparición de los síntomas propios de la enfermedad.
Este grupo de enfermedades no se estudia sólo en lo individual, ya que importa, mucho su transmisión a nivel de la comunidad (función de la epidemiología.
Enfermedades Degenerativas:
No son transmisibles, están causadas por trastornos funcionales metabólicos o nutricios que producen alteraciones morfológicas en los tejidos.
Son de lenta evolución, por ello el diagnóstico precoz es de suma importancia en este grupo de enfermedades. Ejemplos: arterioesclerosis, hipertensión arterial, cataratas, ciertos tipos de cáncer.
Otros tipos de enfermedades son:
— enf. metabólicas, ej.: diabetes mellitus, hipotiroidismo.
— enf. neoplásicas, ej.: tumores benignos o malignos (cáncer).
— enf. alérgicas, ej.: asma bronquial.
— enf. por intoxicación, ej.: botulismo, saturnismo.
— enf. mentales, ej.: neurosis, esquizofrenia.
• Definamos algunos términos:
Epidemia: aparición repentina de una enfermedad que se propaga rápidamente, hace un ciclo y desaparece. El número de casos supera ampliamente el promedio esperado para esa enfermedad.
Pandemia: es cuando la epidemia se propaga a otras naciones.
Endemia: es una enfermedad que se da permanentemente en determinadas regiones, porque en ellas se dan las condiciones ecológicas necesarias para el desarrollo de la noxa; las endemias pueden en cualquier momento convertirse en epidemias.
Zoonosis: son enfermedades que pueden padecer tanto los seres humanos como los animales.
Epizootia: se produce cuando los agentes patógenos atacan a los animales; en algunos casos puede preceder a las epidemias, ya que los animales son víctimas de las mismas noxas que atacan al hombre.
Vectores: Se llaman así a los portadores o transmisores de agentes patógenos; en su mayoría son artrópodos, especialmente insectos; por ejemplo las vinchucas transmisoras del mal de Chagas-Mazza; la hembra del mosquito anopheles que transmite el paludismo.

- Peste Negra en la Edad Media
Las enfermedades epidémicas: La Peste Bubónica
La más temible seguía siendo la peste, que continuaba aterrorizando las poblaciones.
Repugnaba a la gente llamarla por su nombre y la llamaban «el contagio».
Se había propagado desde Oriente donde era endémica, como consecuencia de los grandes peregrinajes como el de la Meca.
Las epidemias son numerosas: en Francia se cuentan 76 entre 1600 y 1786. En 1605, una de ellas obliga a Enrique IV a abandonar París y refugiarse en Fontainebleau.
En 1623, y después de 1629 a 1631 diezma Inglaterra, luego Holanda, Venecia en 1630, Nimega, donde la describe Diemerbroeck, Rotterdam, de donde pasa a Londres a finales de 1664.
Entre el 8 de agosto y el 10 de noviembre de 1665 se registran alrededor de unos 50.000 muertos y la epidemia no se acaba hasta después del gran incendio que, en 1666, destruye la ciudad.
En 1709 la peste ataca a Austria, luego a Prusia, después, en 1763, Ucrania, Sicilia, Provenza y Marsella.
El desastre sufrido por esta provincia sigue siendo tristemente célebre.
Entre 1756 y 1763 diezma los ejércitos de Federico II.
Se encarniza con Moscú, Polonia, entre 1789 y 1801, y un viejo dicho decía «cuando la peste asola un país un tercio de la población muere, otro está enfermo y el tercero queda indemne, entierra los muertos y asegura la continuidad del país».
Reaparece en Egipto en 1799, ataca el ejército francés de Oriente y mata en el Cairo a más de 100.000 habitantes.
Se la vuelve a encontrar en Crimea: en 1812 impide al duque de Richelieu, gobernador de la provincia, reunirse con el emperador Alejandro durante la campaña. Se manifiesta en este caso «no sólo mejor que los demás, sino, si fuera posible, mejor que sí mismo» (Joseph de Maistre).
Después prácticamente la peste desaparece de nuestras regiones, y para explicar este hecho se invoca hoy a las medidas colectivas de higiene puestas en práctica y sobre todo a la desaparición de las ratas negras, familiares en las viviendas, expulsadas por las ratas marrones que temían la proximidad de los hombres y vivían en las alcantarillas.
«Mahoma legó este azote a sus prosélitos y entre los musulmanes la peste no muere. Si no planea sobre los turbantes de Constantinopla, se encuentra en los bonetes de lana de Chiraz y Chezar, si no destruye los campamentos de los tártaros en las orillas del Baikal, lleva a cabo sus estragos en los harenes de Marruecos.
Si no se encuentra en Marruecos, está en El Cairo, si no está en El Cairo, fuerza la paz de los bárbaros rivales de Túnez y Trípoli diezmando sus poblaciones, pero sobrevive, está siempre activa...
Cada viento que sopla puede llevarla en una balandra del Mediterráneo, que lleva de todo, con un capitán de Levante, que jurará todo lo que se le pida, un buhonero judío que compra todo lo que le quieran vender.
De este modo la peste puede insuflar la mortalidad en todo momento, empezando por el campesino en su cabaña o por el Papa desde Loreto a Civitá-Vecchia hasta el Vaticano.»
Estas líneas demuestran la persistencia de la plaga en Asia, su ubicuidad y el peligro permanente que hace correr a Occidente.
Se sabía que las epidemias se iniciaban en los puertos la mayoría de las veces y desde allí se propagaban siguiendo los ríos y los caminos.
El modo en que alcanzó Marsella es característico.
Es interesante conocer las reacciones de los individuos sobre este azote18. Veremos un ejemplo en ocasión de la gran peste de Londres de 1665, remitiéndonos a la sobrecogedora descripción que dejó Defoe inspirada por Sydenham.
El gobierno ha abandonado la ciudad.
Los habitantes que no han podido huir por falta de caballos, afectados de una auténtica psicosis, se precipitan sobre los charlatanes, echadores de cartas que les venden a precio de oro amuletos, talismanes, remedios protectores (tales como brazales de cangrejos putrefactos, cuyo olor debía de alejar el mal).
Otros circulan por las calles, evitando todo contacto con los demás; otros acumulan provisiones y se encierran en sus casas, otros, finalmente, cargados con sus trastos, intentan abandonar la ciudad a pie o embarcarse en barcos anclados en el Támesis, si bien lo más frecuente es que fueran rechazados sin piedad.
Las falsas noticias corren de boca en boca.
En determinados momentos un auténtico estupor ataca a la multitud y en otros ésta sufre un auténtico delirio de persecución.
Se recoge en los templos y las iglesias para rogar a Dios que la salve. Se producen escenas horribles.
Los enfermeros abrevian los días de aquellos que tienen que cuidar.
Las casas abandonadas son víctimas del pillaje.
Las comadronas o bien se han marchado o han sucumbido y uno puede figurarse la angustia de las mujeres que se encuentran de parto desprovistas de toda asistencia. Los actos más cobardes y los más sublimes tienen lugar.
El problema de las inhumaciones es trágico.
Los enterradores, llamados «cuervos», se llevan los cuerpos de las 4.000 personas que mueren por semana, sin ataúd, en unos carros especiales y los depositan en unas grandes fosas que podían contener unos sesenta cadáveres.
La mortalidad considerable era de un 70 a un 80 %. Los mismos problemas se encuentran en Marsella en 1720.
A parte de los dramas familiares hay que imaginarse el trastorno económico.
En Londres la vida se detiene, el puerto se cierra, las escuelas, los lugares de espectáculos, los comercios se cierran.
No hay trabajo, no hay comercio; la situación económica se vuelve muy grave, en particular en lo que concierne al abastecimiento, y el hambre amenaza.
Numerosas memorias describen la epidemia que azotó al ejército francés de Oriente en 1799.
Destacaremos solamente la visita a los apestados del hospital de Jaffa realizada por Bonaparte, el valor de Desgenettes que, ante todo el ejército, se inoculó con una lanceta, que acababa de abrir el bubón de un apestado convaleciente, y su atrevida respuesta a Bonaparte que le pedía acabara los días de algunos enfermos intrasportables dándoles opio a grandes dosis: «Mi deber es conservarlos», le declaró.
En un plano general hasta este punto, las consecuencias mortíferas de estas epidemias son catastróficas: desintegración de relaciones sociales, detención de la economía, desaparición de numerosos elementos activos de la población, resultados demográficos muy graves por los cuales determinados pueblos cruelmente afectados jamás pudieron recuperar su estado anterior.
La mano de obra ya no existe, los salarios se elevan.
Los campos, aunque menos afectados que las ciudades, se despueblan en beneficio de estas últimas.
La producción agrícola disminuye, de ahí las hambres.
Pero se dan también otras consecuencias morales y sociales.
Durante las epidemias la lujuria y la embriaguez hacen estragos.
La degradación de las costumbres y de la disciplina social son considerables.
Después, una vez terminada la epidemia, se observa un frenesí de Vivir que se manifiesta por medio de la multiplicación de las bodas.
En el plano social, las clases pobres, las más afectadas, son cada vez más hostiles a las clases acomodadas que han podido huir.
Todos acusan a los gobiernos. Además se produce en estos momentos una nueva distribución de la fortuna, factor que favorecerá la formación de la sociedad capitalista, exagerando el desequilibrio entre ricos y pobres.
En efecto, los bienes de los que han sobrevivido aumentan considerablemente como consecuencia de las herencias.
En fin, el patrimonio básico de la Iglesia aumenta como consecuencia de los dones que le ofrecen para recibir protección.
Entre estos millones de muertos se hallaban sin duda hombres que no habían dado todavía prueba de sus talentos y la desaparición de estas esperanzas retrasaron la evolución moral e intelectual de la humanidad.
No hay que olvidar que ante el número de decesos y la falta de personal los registros parroquiales, con frecuencia, no se podían poner al día.
Estas epidemias permiten numerosas observaciones:
— Las medidas de limpieza son eficaces y de este modo en el año 1720, en Marsella, se salva el Monasterio de San Víctor.
— Desgenettes insiste en el papel del exceso de gente en locales insalubres.
— Se sabe que la enfermedad ataca preferentemente a ciertas profesiones, en primer lugar aquellas cuyos miembros se solicita acudan a cuidar a los apestados, después los descuartizadores de animales, los carniceros y los molineros. En cambio los marineros consignados en sus barcos son relativamente respetados.
— En 1629, en Montpellier, Ronchin observa, sin sacar ninguna conclusión, la existencia, en el momento de una epidemia, de numerosos cadáveres de ratas.
— Se constata que el haber sufrido una vez de la peste no impedía volverla a sufrir de nuevo.
Pugnet, luego Desgenettes, en el momento de la expedición a Egipto, no ignoran que la inoculación del pus de un bubón en período agudo puede ser mortal, mientras que, en cambio, la del pus de un bubón de convaleciente no lo es.
• Era normal buscar la causa de la plaga.
El primer acusado fue la cólera divina. Diembroeck en 1655, Roussel en 1701, Fischer en 1710, luego monseñor de Belzunce la invocan y el papel de Dios es recordado por el poeta:
«Un mal que extiende el terror
mal que el cielo en su furor
inventó por castigar los crímenes de la tierra.»
Se comprende, pues, las invocaciones a ciertos santos: San Roque, San Sebastián, San Nicolás, Santa Úrsula, San Prudencio, San Carlos Borromeo.
También se suplicaba a la Virgen del Manto.
Se pedía, pues, a los santos que desviaran la cólera del Señor. Así se explica la representación de la Pasión en Oberammergau (1629), la bravata de Frejus, las procesiones de Ham en Heure (1638), la construcción de capillas, iglesias, etc.
Luego se incrimina al diablo: en Milán se vio al Maligno engrasar las puertas de ciertas casas, y en el Tirol circular el fantasma de la peste, etc.
Se hace desempeñar un papel a los años bisiestos, a los eclipses. En Londres aparece en el cielo una espada llameante con la punta vuelta hacia la tierra, etc.
Pero era natural que se acusara una intervención humana: los maleficios, los aojamientos, «los engrasadores» que señalan las casas que deben ser afectadas y había que encontrar: «Este pelado, este sarnoso, de donde venía todo el mal.»
También se acusó a los leprosos, a los bohemios y sobre todo a los judíos. Numerosos de ellos fueron víctimas inocentes de la cólera popular.
Algunos, incluso, en Milán, fueron condenados por los tribunales.
Pero pronto otras causas pasarán a ocupar el primer lugar. En 1626, después en 1669, Jouyce y luego Rainsant defienden la idea de contagio en Reims.
En 1608, Nicolás de Lambeling otorga un papel importante al aire contaminado. En 1620, Lempriére, al polvo procedente de los minerales, etc. Pero a principios del siglo XVIII «los contagionistas» y los «no contagionistas» se enfrentan todavía.
Algunos intentan ir aún más lejos. Así, en el siglo XVII, Charles de l'Orme escribe «no es insensato creer que numerosas fiebres agotadoras y mortales se deben a elementos vivos y destructores».
• El Microscopio
En Holanda, Leeuwenhoek obtiene en el microscopio la revelación de «miserables pequeñas bestezuelas», pero no saca de ello ninguna conclusión.
En 1657, el jesuita Athanase Kircher, en Roma, acusa a unos elementos tan pequeños que en el microscopio parecen átomos.
Pero estas nociones no eran exclusivas de la peste y, volviendo a esta última, en 1720, Goiffon intuyó su origen creyendo en la existencia de cuerpos invisibles, tan pequeños son, de un virus responsable de la enfermedad y, al mismo tiempo, por primera vez llama la atención sobre los insectos comensales de los enfermos.
En el siglo XVIII Reinar y luego Linné acusan a los infusorios.
Aunque se desconoce la causa se intenta tomar medidas para evitar el azote de la propagación.
Durante mucho tiempo no había más que un medio de escapar: la fuga; pero, haciendo esto, los fugitivos propagan la epidemia en el campo y la ciudad.
También se llega a interceptar los caminos.
Otra solución es encerrarse en su casa y no salir.
Para suprimir lo olores acusados de propagar la enfermedad, Diermerbroeck, en Nimega, aconseja el tabaco.
Otros recurren a los perfumes: canela, moscada, etc., y es buscando productos más activos como se descubre el agua de colonia.
Se emplea mucho el vinagre aromatizado, pero la sustancia que goza de mayor reputación es el ámbar que, en Francia, se reservó para la familia real.
Las medidas colectivas son, en primer término, medidas locales.
En caso de epidemia se cierran las puertas de la ciudad, así es como el 11 de enero de 1964 el señor de Coulanges escribe al señor de Lamoignon que hallándose la peste en Nápoles cerraron las puertas de Roma, y sólo autorizaba la entrada a los portadores del boletín de salud.
En Francia se toman las primeras grandes medidas preventivas en Lyon, con motivo de la epidemia de 1628. Se crea un despacho de salud, que dicta una serie de reglas muy estrictas.
Además de cerrar las puertas de la ciudad se cierran las casas de los enfermos y todos los que han estado en contacto con ellos son puestos en cuarentena25. Los ropajes y ropa interior de los apestados se queman.
Se desinfecta con grandes fuegos hechos de gavillas de paja rociadas de perfume o de azufre. Ante las puertas, en las calles y las plazas se encienden otros fuegos. Se lavan los suelos con vinagre, se entierran profundamente las basuras y deshechos.
Se aísla a los mendigos y se acorrala a los animales domésticos. Se prohíben las reuniones.
El conjunto de estas reglas lo recogió en 1629 Gaspard Chevalier y luego Guibert.
A todo esto hay que añadir la vigilancia de las ferias.
Estas medidas fueron eficaces, ya que en 1720, a pesar de la llegada a Lyon de numerosos marselleses huidos de su ciudad, no se observó ningún caso de peste.
En 1635, en Nancy, los médicos tenían la obligación de declarar los casos de enfermedad.
En Londres se tomaron medidas draconianas en 1665.
Estaba prohibido salir de las casas contaminadas, vigiladas por guardias que aseguraban el revituallamiento e impedían toda comunicación con el exterior.
Las puertas de estas casas estaban marcadas con una cruz roja sobre la que figuraba la inscripción: «Dios tenga piedad de nosotros.»
En París, en 1607, se había construido el hospital de San Luis para los apestados.
Pero debido a su número era imposible acogerlos a todos.
Bajo el reinado de Luis XIII, Charles de l'Orme había imaginado un vestido especial destinado a proteger a los médicos que se ocupaban de las víctimas de la peste.
Las pérdidas en el cuerpo médico fueron muy graves.
En Londres secundaron a los médicos los farmacéuticos, con toda abnegación, y en Marsella, sus compadres de Montpellier, llegados espontáneamente en su ayuda, y por los capuchinos, que significaron un auxilio muy eficaz.
Pero pronto se organiza la prevención a nivel internacional, la cuarentena se generaliza.
En cada puerto existen oficinas de salud, cuyos poderes son dictatoriales. Cuando llega un barco éste no tiene derecho a acercarse.
Su capitán desciende hasta un lugar especial, privado de comunicación con el interior del puerto, con su diario de salud.
Si a bordo tiene enfermos uno de los médicos del lazareto va a examinarlos.
Si todo está en regla se da al capitán una patente limpia y se le permite acercarse a tierra y desembarcar sus mercancías.
Si hay alguna duda, el navío permanece en su punto de fondeo, a 100 metros de los muelles.
Si es sospechoso, o si transporta apestados, se consigna que la tripulación se quede a bordo, o en el lazareto y se colocan cordones sanitarios a lo largo de los caminos.
Si el navío viene de un puerto donde hay peste su tripulación y sus pasajeros se ponen en cuarentena por un período variable.
Estas medidas se traducen en un gran malestar para el comercio y basta con leer la correspondencia de Stendhal para darse cuenta de ello.
El tratamiento es inexistente. Charles de l'Orme aconseja el empleo de agua hirviendo. «Gracias a estas precauciones he obtenido resultados considerables, que me han valido el agradecimiento de nuestros reyes, durante la peste de París de 1619.»
Dower recurría a las sangrías de 120 onzas y hacía beber ácido sulfúrico diluido.
De una tripulación de 180 hombres perdió sólo 8 marinos.
A finales del siglo XVIll se limitan a favorecer la supuración de los bubones, punzándolos.
Entonces se desinfecta la llaga con ungüentos a base de acetato de cobre o de mercurio.
Se prescriben sudoríficos a base de salvia y de ruda. Como antídoto se recurre a la triaca. Desgenettes preconiza las bebidas calientes, los baños y las fricciones con aceite, aconsejadas también por Baldwin y el padre de Luis de Pavía.
Fuente Consultada:
Historia Cultural de la Enfermedad Marcel Sendrail
Enlace Externo: Historia de las Pandemias
Temas Relacionados:
Patologias Mas Comunes del Ser Humano
Enfermedades Mentales Psicopatia
Enfermedades sociales Alcoholismo Tabaquismo Drogadiccion
Historia de las Enfermedades en la Edad Moderna
Enlace Externo: • En MedlinePlus hay más información sobre Enfermedad infecciosa